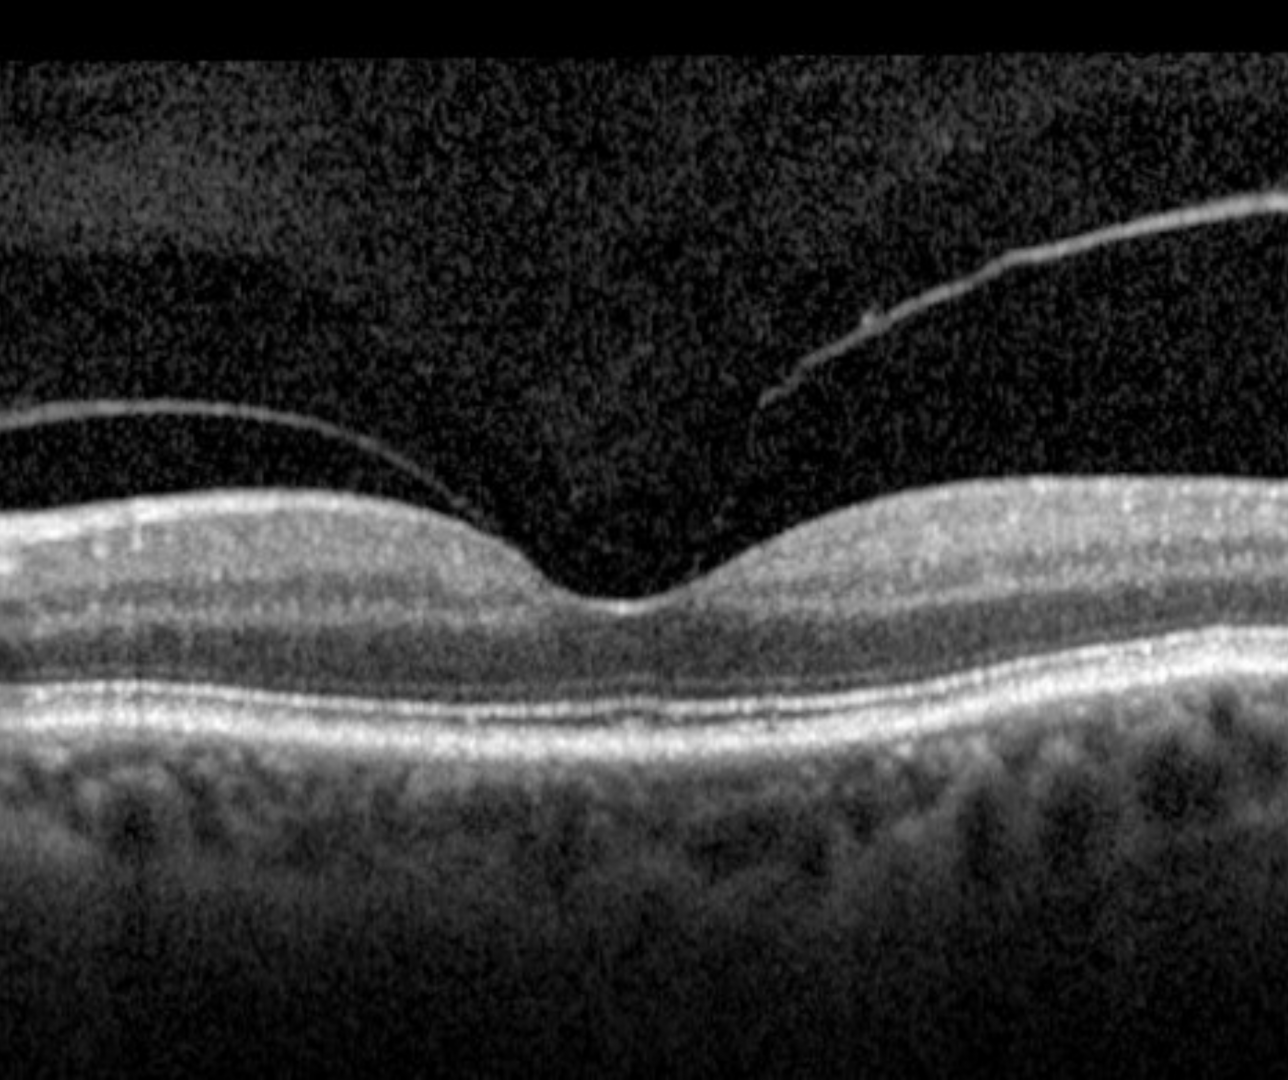

Overview
A posterior vitreous detachment (PVD) is a separation of the posterior vitreous cortex from the inner limiting membrane (ILM). More information about PVD can be found using the link at the bottom of this page.
If the adhesion between the retina and vitreous does not weaken at a suitable rate in a PVD, tractional forces are placed on the retina in the areas of persistent adhesion, causing anomalous PVD. When the persistent adhesion is at the macula, it can cause a range of vitreomacular interface disorders.
The links below provide more information about the wide range of complications that may be induced by anomalous PVD.
Sub-Topics
Background Information
References
Stalmans, P. Duker, J. Kaiser, PK. Heier, JS. Dugel, P et al. (2013) OCT-Based interpretation of the vitreomacular interface and indications for pharmacologic vitreolysis. Retina Volume 33 - Issue 10